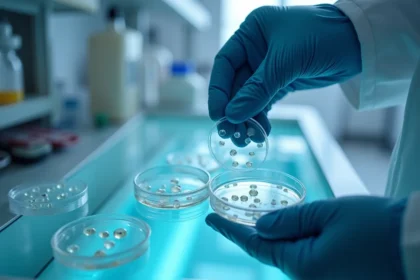
In vitro: Co to jest i jak przebiega proces?

Sorbitol to niskokaloryczny słodzik, który naturalnie występuje w owocach. Jego bezpieczeństwo dla zdrowia sprawia, że zyskuje uznanie w wielu dietach. Jednak warto zrozumieć zarówno jego atuty, jak i...
Obrzezanie to niezwykle interesujący temat, który łączy w sobie różne aspekty – od religijnych, przez kulturowe, aż po zdrowotne. Ma on znaczący wpływ na życie wielu osób na całym świecie. Ludzie pode...
Rektoskopia to szybkie i bezpieczne badanie endoskopowe, które umożliwia szczegółową ocenę błony śluzowej odbytnicy oraz kanału odbytu. Dzięki temu procedura może pomóc w identyfikacji poważnych probl...
Insulinooporność to problem zdrowotny, który zyskuje na znaczeniu w dzisiejszych czasach. To schorzenie metaboliczne może prowadzić do poważnych komplikacji, w tym do cukrzycy typu 2, co czyni zrozumi...
Test Combo to nowoczesne narzędzie diagnostyczne, które pozwala na jednoczesne wykrywanie wielu wirusów, w tym: SARS-CoV-2, wirusów grypy A, wirusów grypy B. Dzięki temu staje się niezwykle efektywny ...
Zespół policystycznych jajników (PCOS) to problem, który dotyka około 10% kobiet w wieku rozrodczym. Osoby z tym schorzeniem często zmagają się z: nieregularnymi cyklami miesiączkowymi, nadmiernym owł...
Tauryna to niezwykle ważny aminokwas, który odgrywa istotną rolę w funkcjonowaniu naszego ciała. Pomaga w utrzymaniu zdrowia i zwiększa naszą wydolność. Warto zwrócić uwagę na naturalne źródła tauryny...
Wirus RSV, znany jako wirus syncytialny układu oddechowego, to jeden z najczęstszych sprawców infekcji dróg oddechowych. Jest szczególnie niebezpieczny dla: najmłodszych, osób w podeszłym wieku, osób ...
Czy kiedykolwiek myślałeś o okularach progresywnych? Te wyjątkowe soczewki mogą znacznie poprawić Twoje codzienne życie. Dzięki nim możesz cieszyć się: komfortowym widzeniem na różnych dystansach, bra...
Zapłodnienie in vitro, znane jako IVF, to nowoczesna metoda, która może pomóc parom w realizacji ich marzeń o posiadaniu dzieci. Cały proces obejmuje: stymulację hormonalną, dokładne zapłodnienie komó...